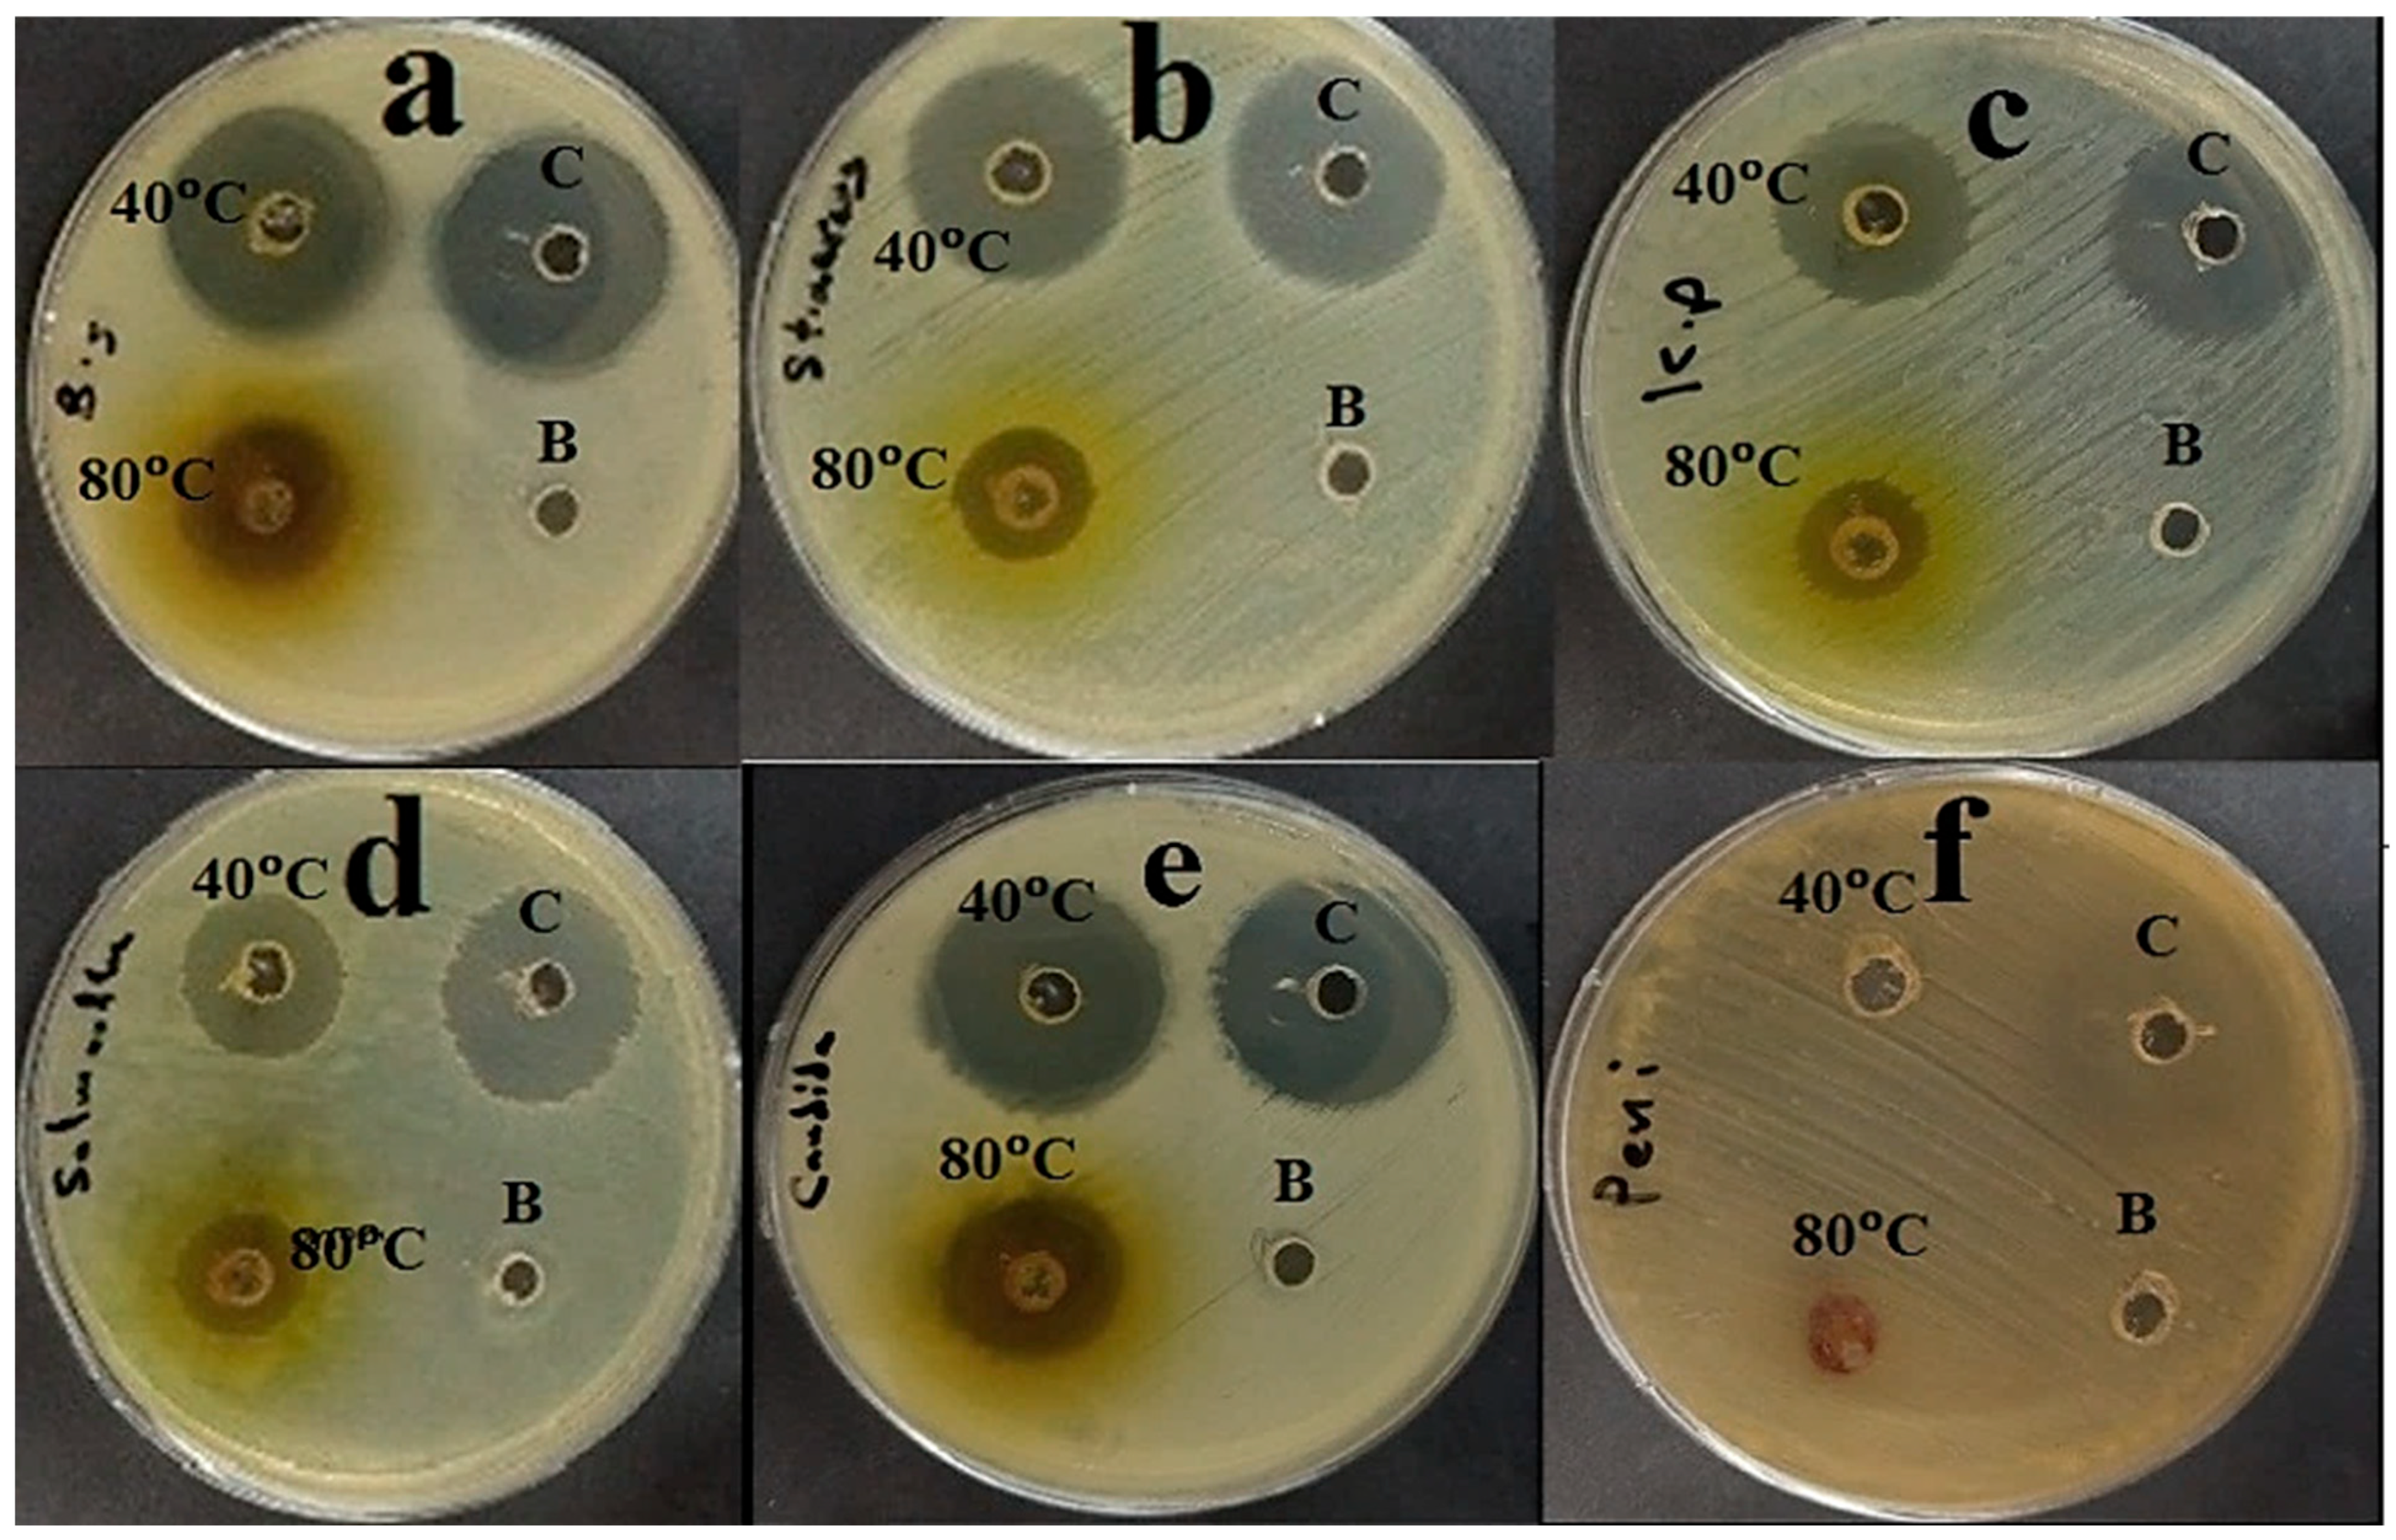
Plants 14 01813 g004

Therapeutic Potential of Plantago ovata Bioactive Extracts Obtained by Supercritical Fluid Extraction as Influenced by Temperature on Anti-Obesity, Anticancer, and Antimicrobial Activities
Abstract
1. Introduction
2. Results and Discussion
2.1. Supercritical Fluid Extraction (SFE) of Leaves
2.2. HPLC Analysis of P. ovata SFEs
2.3. Assay of Antimicrobial Activity
2.4. Determination of MICs and MBCs of P. ovata Extracts
2.5. Assay of Pancreatic Lipase Inhibition
2.6. Cytotoxicity Test
3. Materials and Methods
3.1. Plant Materials, Chemical Reagents, and Cell Line Used
3.2. Supercritical Fluid Extraction (SFE) of Leaves
3.3. HPLC Analysis of P. ovata SFEs
3.4. Assessment of Antimicrobial Potential
3.5. MIC Determination of P. ovata Extracts
3.6. MBC Determination of P. ovata Extracts
3.7. Assay of Pancreatic Lipase Inhibition
3.8. Cytotoxicity Test
3.9. Statistical Analysis
4. Conclusions
Author Contributions
Funding
Data Availability Statement
Acknowledgments
Conflicts of Interest
References
- Pham, B.N.; Jorry, R.; Abori, N.; Silas, V.D.; Okely, A.D.; Pomat, W. Non-communicable diseases attributed mortality and associated sociodemographic factors in Papua New Guinea: Evidence from the Comprehensive Health and Epidemiological Surveillance System. PLoS Glob. Public Health 2022, 2, e0000118. [Google Scholar] [CrossRef] [PubMed]
- Hildebrand, S.; Pfeifer, A. The obesity pandemic and its impact on non-communicable disease burden. Pflügers Arch. Eur. J. Physiol. 2025, 477, 657–668. [Google Scholar] [CrossRef] [PubMed]
- Powell-Wiley, T.M.; Poirier, P.; Burke, L.E.; Després, J.P.; Gordon-Larsen, P.; Lavie, C.J.; Lear, S.A.; Ndumele, C.E.; Neeland, I.J.; Sanders, P.; et al. Obesity and Cardiovascular Disease: A Scientific Statement From the American Heart Association. Circulation 2021, 143, e984–e1010. [Google Scholar] [CrossRef]
- WOA. World Obesity Atlas 2024: No Area of the World Is Unaffected by the Consequences of Obesity. Available online: https://www.worldobesity.org/news/world-obesity-atlas-2024 (accessed on 20 April 2025).
- Safaei, M.; Sundararajan, E.A.; Driss, M.; Boulila, W.; Shapi’i, A. A systematic literature review on obesity: Understanding the causes & consequences of obesity and reviewing various machine learning approaches used to predict obesity. Comput. Biol. Med. 2021, 136, 104754. [Google Scholar] [CrossRef]
- Haththotuwa, R.N.; Wijeyaratne, C.N.; Senarath, U. Chapter 1—Worldwide epidemic of obesity. In Obesity and Obstetrics, 2nd ed.; Mahmood, T.A., Arulkumaran, S., Chervenak, F.A., Eds.; Elsevier: Amsterdam, The Netherlands, 2020; pp. 3–8. [Google Scholar]
- Ren, J.; Tang, W.; Barton, C.D.; Price, O.M.; Mortensen, M.W.; Phillips, A.; Wald, B.; Hulme, S.E.; Stanley, L.P.; Hevel, J.; et al. A highly versatile fungal glucosyltransferase for specific production of quercetin-7-O-β-D-glucoside and quercetin-3-O-β-D-glucoside in different hosts. Appl. Microbiol. Biotechnol. 2022, 106, 227–245. [Google Scholar] [CrossRef]
- Michalakis, K.; Ilias, I. SARS-CoV-2 infection and obesity: Common inflammatory and metabolic aspects. Diabetes Metab. Syndr. 2020, 14, 469–471. [Google Scholar] [CrossRef] [PubMed]
- Wu, H.; Ballantyne, C.M. Metabolic Inflammation and Insulin Resistance in Obesity. Circ. Res. 2020, 126, 1549–1564. [Google Scholar] [CrossRef]
- Rakib, A.; Al Mamun, M.A.; Mandal, M.; Sinha, P.; Singh, U.P. Obesity–cancer axis crosstalk: Molecular insights and therapeutic approaches. Acta Pharm. Sin. B, 2025; in press. [Google Scholar] [CrossRef]
- Binsaleh, N.K.; Bazaid, A.S.; Barnawi, H.; Alharbi, B.; Alsolami, A.; Babsail, A.Y.; Selim, S.; Abdelghany, T.M.; Elbaz, R.M.; Qanash, H. Chemical characterization, anticancer, antioxidant and anti-obesity activities with molecular docking studies of Pleurotus ostreatus biomass exposed to moist heat. J. Food Meas. Charact. 2025, 19, 2476–2495. [Google Scholar] [CrossRef]
- Modak, S.; Aktar, T.; Majumder, D.; Singha, A.K.; Maiti, D. A systemic review on leptin’s role in defining cancer: Special emphasis on immunomodulation, inflammation, and therapeutic interventions. Genes Immun. 2025; online ahead of print. [Google Scholar] [CrossRef]
- Li, Q.; Geng, S.; Luo, H.; Wang, W.; Mo, Y.-Q.; Luo, Q.; Wang, L.; Song, G.-B.; Sheng, J.-P.; Xu, B. Signaling pathways involved in colorectal cancer: Pathogenesis and targeted therapy. Signal Transduct. Target. Ther. 2024, 9, 266. [Google Scholar] [CrossRef]
- Ye, P.; Xi, Y.; Huang, Z.; Xu, P. Linking Obesity with Colorectal Cancer: Epidemiology and Mechanistic Insights. Cancers 2020, 12, 1408. [Google Scholar] [CrossRef]
- Tchang, B.G.; Aras, M.; Kumar, R.B.; Aronne, L.J. Pharmacologic Treatment of Overweight and Obesity in Adults. In Endotext; Feingold, K.R., Ahmed, S.F., Anawalt, B., Blackman, M.R., Boyce, A., Chrousos, G., Corpas, E., de Herder, W.W., Dhatariya, K., Dungan, K., et al., Eds.; MDText.com, Inc.: South Dartmouth, MA, USA, 2000. [Google Scholar]
- Liu, T.-T.; Liu, X.-T.; Chen, Q.-X.; Shi, Y. Lipase Inhibitors for Obesity: A Review. Biomed. Pharmacother. 2020, 128, 110314. [Google Scholar] [CrossRef] [PubMed]
- Johnson, V.R.; Washington, T.B.; Chhabria, S.; Wang, E.H.; Czepiel, K.; Reyes, K.J.C.; Stanford, F.C. Food as Medicine for Obesity Treatment and Management. Clin. Ther. 2022, 44, 671–681. [Google Scholar] [CrossRef] [PubMed]
- Calcaterra, V.; Rossi, V.; Mari, A.; Casini, F.; Bergamaschi, F.; Zuccotti, G.V.; Fabiano, V. Medical treatment of weight loss in children and adolescents with obesity. Pharmacol. Res. 2022, 185, 106471. [Google Scholar] [CrossRef]
- Sun, N.N.; Wu, T.Y.; Chau, C.F. Natural Dietary and Herbal Products in Anti-Obesity Treatment. Molecules 2016, 21, 1351. [Google Scholar] [CrossRef] [PubMed]
- Jamous, R.M.; Abu-Zaitoun, S.Y.; Akkawi, R.J.; Ali-Shtayeh, M.S. Antiobesity and Antioxidant Potentials of Selected Palestinian Medicinal Plants. Evid. Based Complement. Altern. Med. 2018, 2018, 8426752. [Google Scholar] [CrossRef]
- Reynolds, A.; Mann, J.; Cummings, J.; Winter, N.; Mete, E.; Te Morenga, L. Carbohydrate quality and human health: A series of systematic reviews and meta-analyses. Lancet 2019, 393, 434–445. [Google Scholar] [CrossRef]
- Yang, H.; Yang, H.; Zhu, C.; Fan, D.; Deng, J. Highly expandable edible hydrogels for the prevention and treatment of obesity through dietary intervention. Food Hydrocoll. 2023, 144, 108946. [Google Scholar] [CrossRef]
- Panda, H. Medicinal Plants Cultivation and their Uses; Asia Pacific Business Press Inc.: Delhi, Italy, 2002. [Google Scholar]
- Haddadian, K.; Zahmatkash, M. A review of Plantago plant. Indian J. Tradit. Knowl. 2014, 13, 681–685. [Google Scholar]
- Franco, E.A.N.; Sanches-Silva, A.; Ribeiro-Santos, R.; de Melo, N.R. Psyllium (Plantago ovata Forsk): From evidence of health benefits to its food application. Trends Food Sci. Technol. 2020, 96, 166–175. [Google Scholar] [CrossRef]
- Trumbo, P.; Schlicker, S.; Yates, A.A.; Poos, M. Dietary reference intakes for energy, carbohydrate, fiber, fat, fatty acids, cholesterol, protein and amino acids. J. Am. Diet. Assoc. 2002, 102, 1621–1630. [Google Scholar] [CrossRef]
- Calderon, G.; Patel, C.; Camilleri, M.; James-Stevenson, T.; Bohm, M.; Siwiec, R.; Rogers, N.; Wo, J.; Lockett, C.; Gupta, A.; et al. Associations of Habitual Dietary Intake With Fecal Short-Chain Fatty Acids and Bowel Functions in Irritable Bowel Syndrome. J. Clin. Gastroenterol. 2022, 56, 234–242. [Google Scholar] [CrossRef] [PubMed]
- Gautam, R.; Chapagain, M.L.; Acharya, A.; Rayamajhi, N.; Shrestha, S.; Ansari, S.; Upadhaya, G.; Nepal, H.P. Antimicrobial Susceptibility Patterns of Escherichia Coli From Various Clinical Sources. J. Chitwan Med. Coll. 2013, 3, 14–17. [Google Scholar] [CrossRef]
- Amin, M.; Rakhisi, Z.; Zarei-Ahmady, A. Isolation and Identification of Bacillus Species From Soil and Evaluation of Their Antibacterial Properties. Avicenna J. Clin. Microbiol. Infect. 2015, 2, 23233. [Google Scholar] [CrossRef]
- Gono, R.; Sichewo, P.; Mungadzi, W.; Muzvondiwa, J. Isolation and identificatio of pathogenic bacteria in edible fish: A case study of rural aquaculture projects feeding livestock manure to fish in Zimbabwe. Int. J. Curr. Microbiol. Appl. Sci. 2014, 3, 2319–7706. [Google Scholar]
- Al-Mariri, A.; Safi, M. In Vitro Antibacterial Activity of Several Plant Extracts and Oils against Some Gram-Negative Bacteria. Iran. J. Med. Sci. 2014, 39, 36–43. [Google Scholar] [PubMed]
- Viganó, J.; Machado, A.P.d.F.; Martínez, J. Sub- and supercritical fluid technology applied to food waste processing. J. Supercrit. Fluids 2015, 96, 272–286. [Google Scholar] [CrossRef]
- Cabeza, L.F.; de Gracia, A.; Fernández, A.I.; Farid, M.M. Supercritical CO2 as heat transfer fluid: A review. Appl. Therm. Eng. 2017, 125, 799–810. [Google Scholar] [CrossRef]
- Safapuri, T.; Masoodi, F.A.; Rather, S.; Wani, S.; Gull, A. Supercritical Fluid Extraction: A Review. Biol. Chem. Chron. 2019, 5, 114–122. [Google Scholar]
- Jiménez-Sánchez, C.; Lozano-Sánchez, J.; Segura-Carretero, A.; Fernández-Gutiérrez, A. Alternatives to conventional thermal treatments in fruit-juice processing. Part 2: Effect on composition, phytochemical content, and physicochemical, rheological, and organoleptic properties of fruit juices. Crit. Rev. Food Sci. Nutr. 2017, 57, 637–652. [Google Scholar] [CrossRef]
- Rocha, M.E.B.; Kakuda, L.; Souto, E.B.; Oliveira, W.P. Extraction and characterization of Plantago major L. mucilage as a potential natural alternative over synthetic polymers for pharmaceutical formulations. Sustain. Chem. Pharm. 2024, 42, 101764. [Google Scholar] [CrossRef]
- Assi, A.; Kalkan, E.; Maskan, M. Mucilage from Plantago ovata Forsk seed: Optimization of extraction process conditions and investigation of some functional properties. Braz. J. Food Technol. 2024, 27, e2024017. [Google Scholar] [CrossRef]
- Campos, B.E.; Dias Ruivo, T.; da Silva Scapim, M.R.; Madrona, G.S.; de C. Bergamasco, R. Optimization of the mucilage extraction process from chia seeds and application in ice cream as a stabilizer and emulsifier. LWT 2016, 65, 874–883. [Google Scholar] [CrossRef]
- Bazezew, A.M.; Emire, S.A.; Sisay, M.T.; Teshome, P.G. Optimization of mucilage extraction from Ximenia americana seed using response surface methodology. Heliyon 2022, 8, e08781. [Google Scholar] [CrossRef]
- Golalikhani, M.; Khodaiyan, F.; Khosravi, A. Response surface optimization of mucilage aqueous extraction from flixweed (Descurainia sophia) seeds. Int. J. Biol. Macromol. 2014, 70, 444–449. [Google Scholar] [CrossRef] [PubMed]
- Talukder, P.; Talapatra, S.; Ghoshal, N.; Sen Raychaudhuri, S. Antioxidant activity and high-performance liquid chromatographic analysis of phenolic compounds during in vitro callus culture of Plantago ovata Forsk. and effect of exogenous additives on accumulation of phenolic compounds. J. Sci. Food Agric. 2016, 96, 232–244. [Google Scholar] [CrossRef]
- Jaime, L.; Vázquez, E.; Fornari, T.; López-Hazas Mdel, C.; García-Risco, M.R.; Santoyo, S.; Reglero, G. Extraction of functional ingredients from spinach (Spinacia oleracea L.) using liquid solvent and supercritical CO2 extraction. J. Sci. Food Agric. 2015, 95, 722–729. [Google Scholar] [CrossRef]
- Rana, S.; Bhushan, S. Apple phenolics as nutraceuticals: Assessment, analysis and application. J. Food Sci. Technol. 2016, 53, 1727–1738. [Google Scholar] [CrossRef]
- Díaz-de-Cerio, E.; Verardo, V.; Gómez-Caravaca, A.M.; Fernández-Gutiérrez, A.; Segura-Carretero, A. Exploratory Characterization of Phenolic Compounds with Demonstrated Anti-Diabetic Activity in Guava Leaves at Different Oxidation States. Int. J. Mol. Sci. 2016, 17, 699. [Google Scholar] [CrossRef]
- Cejudo-Bastante, M.J.; Durán-Guerrero, E.; Natera-Marín, R.; Castro-Mejías, R.; García-Barroso, C. Characterisation of commercial aromatised vinegars: Phenolic compounds, volatile composition and antioxidant activity. J. Sci. Food Agric. 2013, 93, 1284–1302. [Google Scholar] [CrossRef]
- Ciulu, M.; Cádiz-Gurrea, M.L.; Segura-Carretero, A. Extraction and Analysis of Phenolic Compounds in Rice: A Review. Molecules 2018, 23, 2890. [Google Scholar] [CrossRef]
- Bodoira, R.; Maestri, D. Phenolic Compounds from Nuts: Extraction, Chemical Profiles, and Bioactivity. J. Agric. Food Chem. 2020, 68, 927–942. [Google Scholar] [CrossRef]
- Alu’datt, M.H.; Rababah, T.; Alhamad, M.N.; Al-Mahasneh, M.A.; Almajwal, A.; Gammoh, S.; Ereifej, K.; Johargy, A.; Alli, I. A review of phenolic compounds in oil-bearing plants: Distribution, identification and occurrence of phenolic compounds. Food Chem. 2017, 218, 99–106. [Google Scholar] [CrossRef] [PubMed]
- Hachicha, S.; Debbabi, H.; Jlassi, I.; Joshi, D.R.K.; El Mokni, R. Chemical composition and antimicrobial activity of essential oil from the aerial parts of Plantago afra L. (Plantaginaceae) growing wild in Tunisia. S. Afr. J. Bot. 2020, 132, 410–414. [Google Scholar] [CrossRef]
- Reddy, P.R.T.; Vandana, K.V.; Prakash, S. Antibacterial and anti-inflammatory properties of Plantago ovata Forssk. leaves and seeds against periodontal pathogens: An in vitro study. Ayu 2018, 39, 226–229. [Google Scholar] [CrossRef] [PubMed]
- García-Salinas, S.; Elizondo-Castillo, H.; Arruebo, M.; Mendoza, G.; Irusta, S. Evaluation of the Antimicrobial Activity and Cytotoxicity of Different Components of Natural Origin Present in Essential Oils. Molecules 2018, 23, 1399. [Google Scholar] [CrossRef] [PubMed]
- Alfuraiji, A.E.A.-S.a.N. Medicinal Plants with Anti-Obesity Effects: A Special Emphasis on Their Mode of Action. Bahrain Med. Bull. 2023, 45, 1421–1427. [Google Scholar]
- Bajes, H.R.; Almasri, I.; Bustanji, Y. Plant Products and Their Inhibitory Activity Against Pancreatic Lipase. Rev. Bras. Farmacogn. 2020, 30, 321–330. [Google Scholar] [CrossRef]
- Lunagariya, N.A.; Patel, N.K.; Jagtap, S.C.; Bhutani, K.K. Inhibitors of pancreatic lipase: State of the art and clinical perspectives. Excli J. 2014, 13, 897–921. [Google Scholar]
- Mamdooh, N.; Kasabri, V.; Al-Hiari, Y.; Almasri, I.; Al-Alawi, S.; Bustanji, Y. Evaluation of selected commercial pharmacotherapeutic drugs as potential pancreatic lipase inhibitors and antiproliferative compounds. Drug Dev. Res. 2019, 80, 310–324. [Google Scholar] [CrossRef]
- Singh, A.K.; Singh, R. Pharmacotherapy in obesity: A systematic review and meta-analysis of randomized controlled trials of anti-obesity drugs. Expert. Rev. Clin. Pharmacol. 2020, 13, 53–64. [Google Scholar] [CrossRef]
- Aguilera-Angel, E.-Y.; Espinal-Ruiz, M.; Narváez-Cuenca, C.-E. Pectic polysaccharides with different structural characteristics as inhibitors of pancreatic lipase. Food Hydrocoll. 2018, 83, 229–238. [Google Scholar] [CrossRef]
- Herrera, T.; Navarro del Hierro, J.; Fornari, T.; Reglero, G.; Martin, D. Inhibitory effect of quinoa and fenugreek extracts on pancreatic lipase and α-amylase under in vitro traditional conditions or intestinal simulated conditions. Food Chem. 2019, 270, 509–517. [Google Scholar] [CrossRef]
- Bustanji, Y.; Al-Masri, I.M.; Mohammad, M.; Hudaib, M.; Tawaha, K.; Tarazi, H.; Alkhatib, H.S. Pancreatic lipase inhibition activity of trilactone terpenes of Ginkgo biloba. J. Enzym. Inhib. Med. Chem. 2011, 26, 453–459. [Google Scholar] [CrossRef]
- Liu, P.K.; Weng, Z.M.; Ge, G.B.; Li, H.L.; Ding, L.L.; Dai, Z.R.; Hou, X.D.; Leng, Y.H.; Yu, Y.; Hou, J. Biflavones from Ginkgo biloba as novel pancreatic lipase inhibitors: Inhibition potentials and mechanism. Int. J. Biol. Macromol. 2018, 118, 2216–2223. [Google Scholar] [CrossRef] [PubMed]
- Pereira, M.N.; Justino, A.B.; Martins, M.M.; Peixoto, L.G.; Vilela, D.D.; Santos, P.S.; Teixeira, T.L.; da Silva, C.V.; Goulart, L.R.; Pivatto, M.; et al. Stephalagine, an alkaloid with pancreatic lipase inhibitory activity isolated from the fruit peel of Annona crassiflora Mart. Ind. Crops Prod. 2017, 97, 324–329. [Google Scholar] [CrossRef]
- Chen, G.; Li, H.; Zhao, Y.; Zhu, H.; Cai, E.; Gao, Y.; Liu, S.; Yang, H.; Zhang, L. Saponins from stems and leaves of Panax ginseng prevent obesity via regulating thermogenesis, lipogenesis and lipolysis in high-fat diet-induced obese C57BL/6 mice. Food Chem. Toxicol. 2017, 106, 393–403. [Google Scholar] [CrossRef]
- El-Baz, F.K.; Aly, H.F.; Abd-Alla, H.I. The ameliorating effect of carotenoid rich fraction extracted from Dunaliella salina microalga against inflammation- associated cardiac dysfunction in obese rats. Toxicol. Rep. 2020, 7, 118–124. [Google Scholar] [CrossRef] [PubMed]
- Gálvez, M.; Martín-Cordero, C.; López-Lázaro, M.; Cortés, F.; Ayuso, M.J. Cytotoxic effect of Plantago spp. on cancer cell lines. J. Ethnopharmacol. 2003, 88, 125–130. [Google Scholar] [CrossRef]
- Azmir, J.; Zaidul, I.S.M.; Rahman, M.M.; Sharif, K.M.; Mohamed, A.; Sahena, F.; Jahurul, M.H.A.; Ghafoor, K.; Norulaini, N.A.N.; Omar, A.K.M. Techniques for extraction of bioactive compounds from plant materials: A review. J. Food Eng. 2013, 117, 426–436. [Google Scholar] [CrossRef]
- Souza, G.; Siqueira dos Santos, S.; Bergamasco, R.; Antigo, J.; Madrona, G.S. Antioxidant activity, extraction and application of psyllium mucilage in chocolate drink. Nutr. Food Sci. 2020, 50, 1175–1185. [Google Scholar] [CrossRef]
- Qanash, H.; El-Fadl, S.R.A.; Binsaleh, N.K.; Aljahdali, I.A.; Altayar, M.A.; Khalel, A.F.; Alsalamah, S.A.; Alghonaim, M.I.; Abdelghany, T.M. Ecofriendly extraction approach of Moringa peregrina biomass and their biological activities in vitro. Biomass Convers. Biorefinery 2024, 15, 12205–12215. [Google Scholar] [CrossRef]
- Verni, M.; Pontonio, E.; Krona, A.; Jacob, S.; Pinto, D.; Rinaldi, F.; Verardo, V.; Díaz-de-Cerio, E.; Coda, R.; Rizzello, C.G. Bioprocessing of Brewers’ Spent Grain Enhances Its Antioxidant Activity: Characterization of Phenolic Compounds and Bioactive Peptides. Front. Microbiol. 2020, 11, 1831. [Google Scholar] [CrossRef] [PubMed]
- Anjum, S.; Gani, A.; Ahmad, M.; Shah, A.; Masoodi, F.A.; Shah, Y.; Gani, A. Antioxidant and Antiproliferative Activity of Walnut Extract (Juglans regia L.) Processed by Different Methods and Identification of Compounds Using GC/MS and LC/MS Technique. J. Food Process. Preserv. 2017, 41, e12756. [Google Scholar] [CrossRef]
- Qanash, H.; Bazaid, A.S.; Alharbi, S.F.; Binsaleh, N.K.; Barnawi, H.; Alharbi, B.; Alsolami, A.; Almashjary, M.N. Therapeutic Effects of Nanocoating of Apitoxin (Bee Venom) and Polyvinyl Alcohol Supplemented with Zinc Oxide Nanoparticles. Pharmaceutics 2025, 17, 172. [Google Scholar] [CrossRef]
- Bazaid, A.S.; Binsaleh, N.K.; Barnawi, H.; Alharbi, B.; Alsolami, A.; Selim, S.; Al Jaouni, S.K.; Saddiq, A.A.; Ganash, M.; Abdelghany, T.M.; et al. Unveiling the in vitro activity of extracted Euphorbia trigona via Supercritical Fluid Extraction against pathogenic yeasts, obesity, cancer, and its wound healing properties. Bioresour. Bioprocess. 2025, 12, 28. [Google Scholar] [CrossRef]
- Malm, A.; Glowniak-Lipa, A.; Korona-Glowniak, I.; Baj, T. Anti-Helicobacter pylori activity in vitro of chamomile flowers, coneflower herbs, peppermint leaves and thyme herbs—A preliminary report. Curr. Issues Pharm. Med. Sci. 2015, 28, 30–32. [Google Scholar] [CrossRef]
- Kim, Y.S.; Lee, Y.M.; Kim, H.; Kim, J.; Jang, D.S.; Kim, J.H.; Kim, J.S. Anti-obesity effect of Morus bombycis root extract: Anti-lipase activity and lipolytic effect. J. Ethnopharmacol. 2010, 130, 621–624. [Google Scholar] [CrossRef]
- Tolosa, L.; Donato, M.T.; Gómez-Lechón, M.J. General Cytotoxicity Assessment by Means of the MTT Assay. In Protocols in In Vitro Hepatocyte Research; Vinken, M., Rogiers, V., Eds.; Springer New York: New York, NY, USA, 2015; pp. 333–348. [Google Scholar]
- Slater, T.F.; Sawyer, B.; Straeuli, U. Studies on Succinate-tetrazolium Reductase Systems. III. Points of Coupling of Four Different Tetrazolium Salts. Biochim. Biophys. Acta 1963, 77, 383–393. [Google Scholar] [CrossRef]
- Qanash, H.; Bazaid, A.S.; Binsaleh, N.K.; Patel, M.; Althomali, O.W.; Sheeha, B.B. In Vitro Antiproliferative Apoptosis Induction and Cell Cycle Arrest Potential of Saudi Sidr Honey against Colorectal Cancer. Nutrients 2023, 15, 3448. [Google Scholar] [CrossRef]
- Alley, M.C.; Scudiero, D.A.; Monks, A.; Hursey, M.L.; Czerwinski, M.J.; Fine, D.L.; Abbott, B.J.; Mayo, J.G.; Shoemaker, R.H.; Boyd, M.R. Feasibility of drug screening with panels of human tumor cell lines using a microculture tetrazolium assay. Cancer Res. 1988, 48, 589–601. [Google Scholar]
- Kamiloglu, S.; Sari, G.; Ozdal, T.; Capanoglu, E. Guidelines for cell viability assays. Food Front. 2020, 1, 332–349. [Google Scholar] [CrossRef]
- van de Loosdrecht, A.A.; Beelen, R.H.; Ossenkoppele, G.J.; Broekhoven, M.G.; Langenhuijsen, M.M. A tetrazolium-based colorimetric MTT assay to quantitate human monocyte mediated cytotoxicity against leukemic cells from cell lines and patients with acute myeloid leukemia. J. Immunol. Methods 1994, 174, 311–320. [Google Scholar] [CrossRef] [PubMed]

| Components | Polyphenols | P. ovata SFE 40 °C | P. ovata SFE 80 °C | |||
|---|---|---|---|---|---|---|
| Conc. (µg mL−1) | Area (mAU*s) | Conc. (µg mL−1) | Area (mAU*s) | Conc. (µg mL−1) | Area (mAU*s) | |
| Ellagic acid | 70 | 689.07 | 168.62 | 1659.90 | 290.57 | 2860.32 |
| Gallic acid | 20 | 273.16 | 11.69 | 159.73 | 2.77 | 37.86 |
| Chlorogenic acid | 50 | 358.82 | 18.81 | 134.97 | 5.54 | 39.74 |
| Catechin | 75 | 349.12 | 0.00 | 0.00 | 0.00 | 0.00 |
| Methyl gallate | 15 | 268.08 | 0.06 | 1.15 | 0.00 | 0.00 |
| Caffeic acid | 20 | 389.84 | 123.00 | 2397.53 | 76.51 | 1491.38 |
| Syringic acid | 20 | 340.02 | 5.65 | 96.13 | 1.70 | 28.97 |
| Rutin | 50 | 334.02 | 264.90 | 1769.64 | 75.80 | 506.37 |
| Coumaric acid | 20 | 556.49 | 0.05 | 1.28 | 0.13 | 3.56 |
| Vanillin | 20 | 551.43 | 8.69 | 239.60 | 11.92 | 328.55 |
| Ferulic acid | 20 | 344.53 | 1.01 | 17.39 | 0.00 | 0.00 |
| Naringenin | 30 | 325.05 | 2.07 | 22.40 | 1.35 | 14.57 |
| Kaempferol | 20 | 795.56 | 0.18 | 7.35 | 0.31 | 12.47 |
| Hesperetin | 20 | 427.11 | 3.04 | 64.93 | 0.00 | 0.00 |
| Rosmarinic acid | 50 | 514.83 | 16.10 | 165.74 | 9.83 | 101.19 |
| Daidzein | 20 | 349.30 | 3.43 | 59.88 | 0.11 | 1.94 |
| Quercetin | 40 | 321.17 | 1.82 | 14.59 | 1.31 | 10.52 |
| Cinnamic acid | 10 | 515.96 | 0.19 | 9.75 | 0.19 | 9.80 |
| Total polyphenols | -- | (0.18 g GAE kg−1 FW) | (0.13 g GAE kg−1 FW) | |||
Disclaimer/Publisher’s Note: The statements, opinions and data contained in all publications are solely those of the individual author(s) and contributor(s) and not of MDPI and/or the editor(s). MDPI and/or the editor(s) disclaim responsibility for any injury to people or property resulting from any ideas, methods, instructions or products referred to in the content. |
© 2025 by the authors. Licensee MDPI, Basel, Switzerland. This article is an open access article distributed under the terms and conditions of the Creative Commons Attribution (CC BY) license (https://creativecommons.org/licenses/by/4.0/).
Share and Cite
Qanash, H.; Bazaid, A.S.; Binsaleh, N.K.; Alshammari, A.S.; Eltayeb, R. Therapeutic Potential of Plantago ovata Bioactive Extracts Obtained by Supercritical Fluid Extraction as Influenced by Temperature on Anti-Obesity, Anticancer, and Antimicrobial Activities. Plants 2025, 14, 1813. https://doi.org/10.3390/plants14121813
Qanash H, Bazaid AS, Binsaleh NK, Alshammari AS, Eltayeb R. Therapeutic Potential of Plantago ovata Bioactive Extracts Obtained by Supercritical Fluid Extraction as Influenced by Temperature on Anti-Obesity, Anticancer, and Antimicrobial Activities. Plants. 2025; 14(12):1813. https://doi.org/10.3390/plants14121813
Chicago/Turabian StyleQanash, Husam, Abdulrahman S. Bazaid, Naif K. Binsaleh, Amirah S. Alshammari, and Reem Eltayeb. 2025. "Therapeutic Potential of Plantago ovata Bioactive Extracts Obtained by Supercritical Fluid Extraction as Influenced by Temperature on Anti-Obesity, Anticancer, and Antimicrobial Activities" Plants 14, no. 12: 1813. https://doi.org/10.3390/plants14121813
APA StyleQanash, H., Bazaid, A. S., Binsaleh, N. K., Alshammari, A. S., & Eltayeb, R. (2025). Therapeutic Potential of Plantago ovata Bioactive Extracts Obtained by Supercritical Fluid Extraction as Influenced by Temperature on Anti-Obesity, Anticancer, and Antimicrobial Activities. Plants, 14(12), 1813. https://doi.org/10.3390/plants14121813

